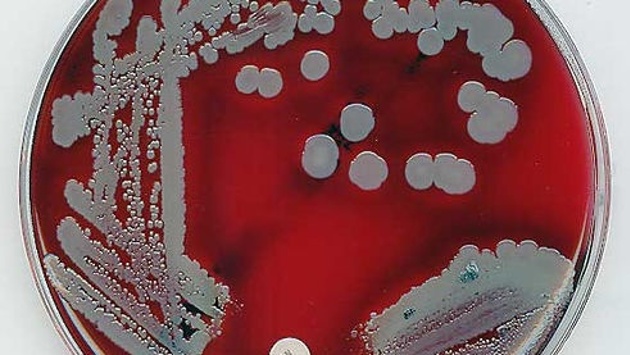

Искусственный интеллект научился распознавать бактерии
Ученые из медицинского центра Бет-Изрейел в Бостоне создали микроскопы с искусственным интеллектом, которые могут сами искать опасные бактерии в образце крови. Результаты опубликованы в Journal of Clinical Microbiology. Об этом сообщает Eurekalert. В условиях нехватки высококвалифицированных микробиологов ставить диагнозы пациентам сложно. Но ученые нашли решение этой проблемы. Они взяли автоматический микроскоп, который может получать фотографии с высоким разрешением, и образцы крови, которые были окрашены, чтобы бактерий стало лучше видно. Затем они использовали сверхточную нейтронную сеть, созданную для распознавания изображений, и натренировали ее распознавать бактерии по их форме и расположению. Исследователи начали с самых часто встречающихся бактерий: кишечной палочки с ее удлиненной формой, стафиллококк, круглые клетки которого растут «гроздьями», а также стрептококк, который может расти парами или цепочками. Из 25 000 изображений, полученных из повседневной клинической практики, ученые сделали более 100 000 картинок для обучения. Искусственный интеллект смог распознать три разновидности бактерий с 95%-ной точностью. Затем исследователи предложили рассортировать 189 образцов безо всякого вмшательства человека. Алгоритм справился с задачей и давал правильные ответы в 93% случаев. «Как ребенок, эта система нуждается в тренировке, – говорит ведущий автор статьи Джеймс Кирби, руководитель Лаборатории клинической микробиологии и профессор Гарвардской медицинской школы. – Обучение требует большого количества практики, система делает много ошибок и учится на них». Быстрая диагностика бактерий в крови может спасти жизни множества людей: сейчас у пациента с заражением крови риск летального исхода равен 40%. По мнению авторов исследования, искусственный интеллект может помочь не только устанавливать причины инфекции в медицинских центрах, где не хватает специалистов-микробиологов, но и может обучать студентов и стажеров.
Исследователи создали математическую модель эпилепсии